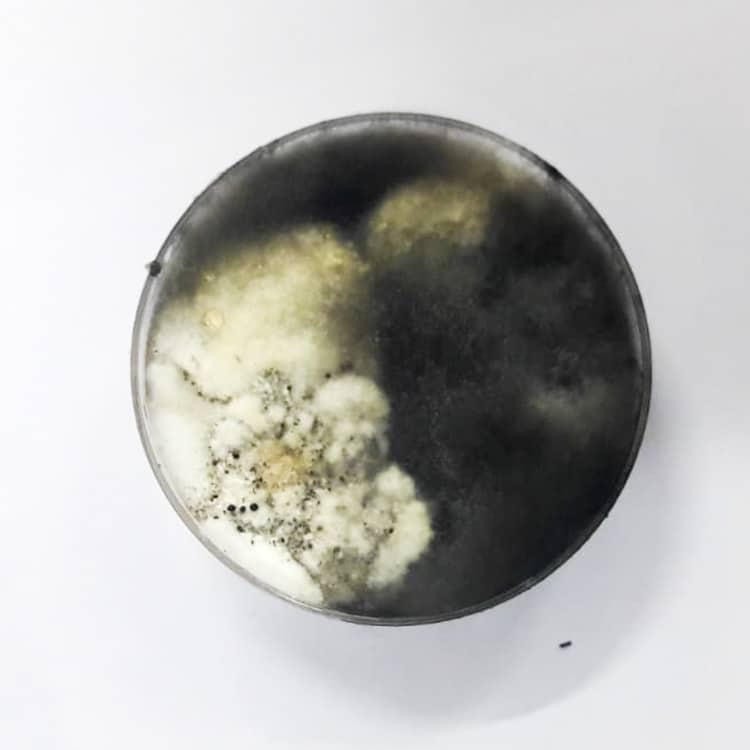

Despite an earthquake, our resilient J.A.M.I.N. students from Port Antonio and Titchfield High Schools were back in their classrooms and ready to investigate the presence of mangrove disease earlier this year. Our students were the first to research the occurrence of mangrove disease in Port Antonio, Jamaica. They were ready and eager to begin.
There were several steps that students executed before they can determine whether the disease-causing fungus, Pestalotiopsis, was present in their samples. Although Jamaican students learn about disease as a part of their Biology syllabus, much of the information that they needed to conduct this investigation was new. With our partners at Alligator Head Foundation, we first provided a lecture about plant disease and demonstrated how to conduct the first part of the investigation.
After the lecture, I held up an agar-filled petri dish for the students to see. They had all used petri dishes before; however, this was the first time that they learned about agar. To satisfy the students’ urge to touch their agar plates during the investigation, which would likely contaminate them, I passed around an example petri dish and asked the students to touch and smell the contents. They passed the petri dish around one by one and made sour facial expressions as they touch the slimy, squishy substance. I explained to the students that the agar was food that the disease-causing pathogens needed to grow. The students nodded their heads in acknowledgment.
We passed out the supplies needed for the activity while the laboratory technician lit the gas flames needed to sterilize the equipment. The students carefully begun cutting the necrotic and healthy tissue from the mangrove leaves that they collected during the field trip. The students then sterilized their tools as the freshly cut leaf fragments were placed in bleach solution to rid them of contaminants. One by one, the students removed the fragments from the solution using the sterilized utensils. With careful precision, they placed the fragments in their agar petri dishes while making sure not to contaminate their samples. Now, all the students had to do was wait for their cultures to grow.
The students analyzed their samples in three different time increments: after 3, 7, and 14 days. They made observations and recorded the results in their mangrove journals.
What Did the Students Find?
Two weeks after the investigation, Alligator Head Foundation returned to the schools to help students determine the results of their investigation. The students identified the various types of fungus that grew in their petri dishes. They even looked at the fungus under a microscope to observe, identify, and illustrate the structures of the sample. The students’ preliminary results showed that there was indeed a presence of disease-causing fungus, Pestalotiopsis, in multiple cultures. Students in our J.A.M.I.N. program were the first to show evidence of this fungus’ existence in Port Antonio, Jamaica. Samples of the fungi cultures will be sent to Dr. Rossi. Using DNA sequencing, she will confirm the students’ visual identification of Pestalotiopsis.
Our mangrove disease activity not only provided Dr. Rossi with scientific data from an area that has never been studied before, but it also allowed J.A.M.I.N. students an opportunity to investigate a real-world problem using scientific inquiry. The students gained new scientific skills, techniques, and knowledge as a part of this investigation. Although we are not enthusiastic to find the presence of Pestalotiopsis in Port Antonio, I am very proud of the diligent effort made by our students to produce solid scientific results. Great job, J.A.M.I.N. participants!